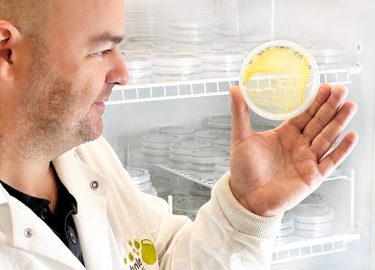
IMG 4302 bob with plate c1v1a

Welcome KAS: Supporting a Transition Towards Natural Astaxanthin
In order to meet the demands of a growing population, S2G believes that aquaculture (done responsibly) can play a critical role in providing sustainable, affordable, and healthy animal protein. Accordingly, aqua farmers today are actively seeking innovative technologies that can help them reduce their impact on the environment, and, of course, lower their costs.
We are thrilled to announce our latest investment in Kuehnle AgroSystems (KAS), a Hawaii-based algal biotech company that is pursuing solutions to these pain points through its novel production process and strain of natural astaxanthin-rich microalgae, an essential feed ingredient in many aquaculture systems.

Scaling Affordable Options to Aquafarmers
Wild salmon and shrimp get their characteristic reddish-pink hue from a diet of carotenoid-rich algae and animals that eat those algae. Farmed salmon naturally lack that distinct color unless provided in their feed. As a result, astaxanthin, the main carotenoid responsible for this trait, is now a critical aquaculture feed ingredient.
Today, most algal astaxanthin is produced in phototropic bioreactors which are costly to construct and require significant energy input and bespoke designs to optimize light exposure. Because of the high cost of naturally produced astaxanthin, 95 percent of what is used in aquafeed is a synthetic version of the carotenoid which is produced through a complex petrochemical process.
KAS is scaling a method that can produce natural astaxanthin at an affordable cost, helping to meet growing demand from farmers looking for sustainable natural inputs for feed. Leveraging a patented dark fermentation process in closed vertical tank systems, KAS’s approach results in higher yields, faster growth times, and lower water and energy consumption.
From the Lab to the Seafood Counter
KAS was founded by Chief Technology Officer Heidi Kuehnle and VP of Operations Gordon Wallace. The company began with a focus on algal biofuel, leading KAS to discover a unique way to produce microalgae with desired traits to meet the needs of a wide variety of specialized global markets.When the team discovered it could achieve high astaxanthin productivity with a strain of Haematococcus pluvialis (HP) algae, it focused commercial efforts on improving this strain and production process.
S2G believes growing consumer and producer preference for natural inputs is expected to help drive the transition from synthetic to natural astaxanthin, and that KAS is strongly positioned to capitalize on this demand. Already, efforts to move towards natural feed additives are underway. In the U.S., all farmed salmon must display “color added” on their label. For organic salmon it is a requirement that only natural astaxanthin is allowed to be added to the feed. Meanwhile, retailer Whole Foods has made an independent commitment only to carry farmed seafood products with natural ingredients.
The company’s $3 million series A2 funding round, led by S2G, will accelerate the commercialization of its method by enabling KAS to leverage contract manufacturers with standard fermentation equipment. KAS will initially launch with its Europe-based production partner this year with the capacity to distribute globally. There is also future potential for recycling the gas generated during fermentation to produce feedstock, which is fed back into the fermentation process, thereby creating fully circular algal products.
We look forward to working with KAS as they continue innovating to sustainably produce microalgae at scale, with wide-reaching implications for the aquaculture industry and beyond.